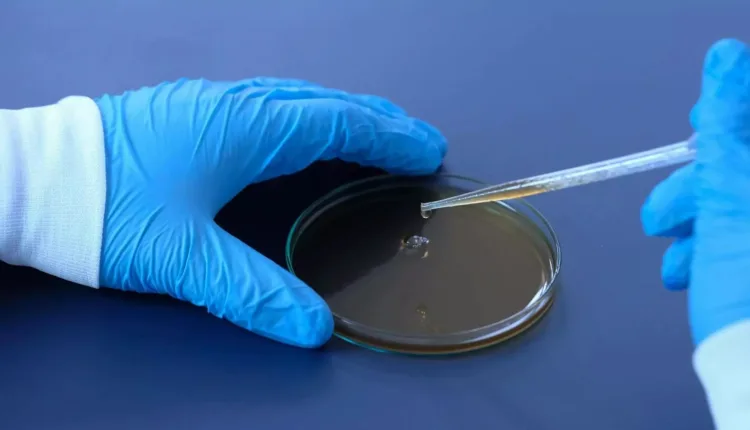
nature-medicine:-Το-εμβόλιο-κατά-του-έρπητα-ζωστήρα-σχετίζεται-με-χαμηλότερο-κίνδυνο-άνοιας

Nature Medicine: Το εμβόλιο κατά του έρπητα ζωστήρα σχετίζεται με χαμηλότερο κίνδυνο άνοιας
To ανασυνδυασμένο εμβόλιο κατά του έρπητα ζωστήρα σχετίζεται με μείωση του κινδύνου άνοιας κατά 17% στα έξι χρόνια μετά τον εμβολιασμό, σύμφωνα με μεγάλη επιδημιολογική μελέτη ηλεκτρονικών δεδομένων υγείας στις ΗΠΑ, που δημοσιεύθηκε στο περιοδικό «Nature Medicine».
Μέχρι σήμερα υπήρξαν ενδείξεις ότι το εμβόλιο κατά του έρπητα ζωστήρα, που περιέχει μία εξασθενημένη εκδοχή του ιού, μπορεί να προσφέρει κάποια προστασία έναντι της άνοιας. Ωστόσο, οι περισσότερες μελέτες που το διερευνούν έγιναν σε μικρά δείγματα πληθυσμού.
Αυτό το εμβόλιο έχει αντικατασταθεί από ένα πιο αποτελεσματικό ανασυνδυασμένο εμβόλιο (περιέχει ένα αντιγόνο από τον ιό του έρπητα ζωστήρα σε συνδυασμό με ένα συστατικό που ενισχύει την ανοσολογική απόκριση), το οποίο δεν είναι σαφές αν έχει παρόμοια αποτελέσματα.
Στην παρούσα έρευνα η επιστημονική ομάδα, με επικεφαλής τον Μαξίμ Τακέ από το Πανεπιστήμιο της Οξφόρδης, ανέλυσε ηλεκτρονικά δεδομένα υγείας στις ΗΠΑ για συνολικά 103.887 άτομα που έλαβαν την πρώτη δόση εμβολίου κατά του έρπητα ζωστήρα μεταξύ 2017 και 2020.
Το 95% αυτών έλαβαν το ανασυνδυασμένο εμβόλιο. Συνέκριναν αυτά τα ευρήματα με δεδομένα για επιπλέον ίσο αριθμό ατόμων που έλαβαν την πρώτη δόση μεταξύ 2014 και 2017, μεταξύ των οποίων το 98% έλαβε το εμβόλιο με ζωντανό ιό.
Όπως διαπίστωσαν, το ανασυνδυασμένο εμβόλιο συσχετίστηκε με χαμηλότερο κίνδυνο άνοιας στα έξι χρόνια μετά τον εμβολιασμό, σε σύγκριση με τον κίνδυνο για όσους έλαβαν το εμβόλιο με ζωντανό ιό, οδηγώντας σε 17% περισσότερο χρόνο ζωής ή 164 επιπλέον ημέρες ζωής χωρίς διάγνωση άνοιας σε όσους προσβλήθηκαν στη συνέχεια. Αυτή η επίδραση παρατηρήθηκε και στα δύο φύλα, αλλά υπήρχε 9% μεγαλύτερη επίδραση στις γυναίκες.
Επιπλέον, και οι δύο τύποι εμβολίου φάνηκε να παρέχουν προστασία έναντι της άνοιας σε σύγκριση με δύο άλλα εμβόλια που λαμβάνουν συχνά οι ηλικιωμένοι, το εμβόλιο κατά τετάνου, διφθερίτιδας και κοκκύτη και το εμβόλιο γρίπης.
Οι ερευνητές υπογραμμίζουν ότι τα ευρήματά τους είναι παρατηρησιακά και πως η αιτιότητα δεν μπορεί να αποδειχθεί. Επίσης, ότι απαιτείται περισσότερη έρευνα για την κατανόηση των παραγόντων που παίζουν ρόλο σε αυτήν τη συσχέτιση.

Τα σχόλια είναι κλειστά.